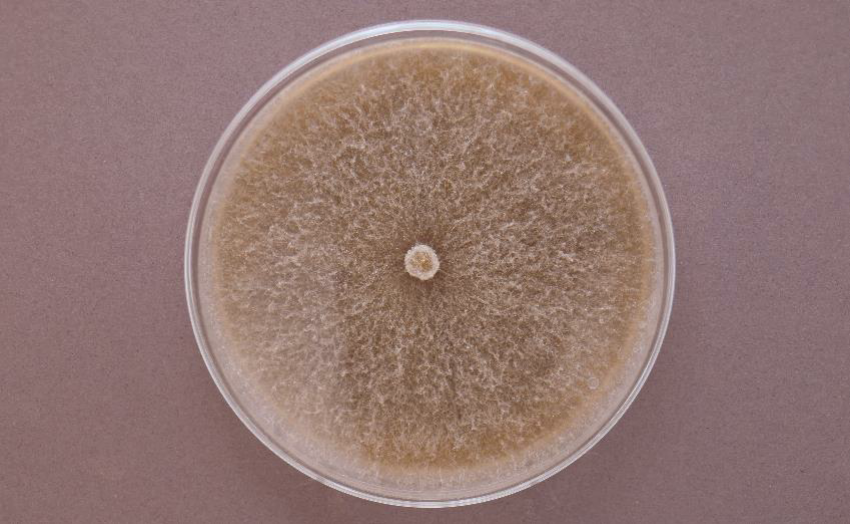
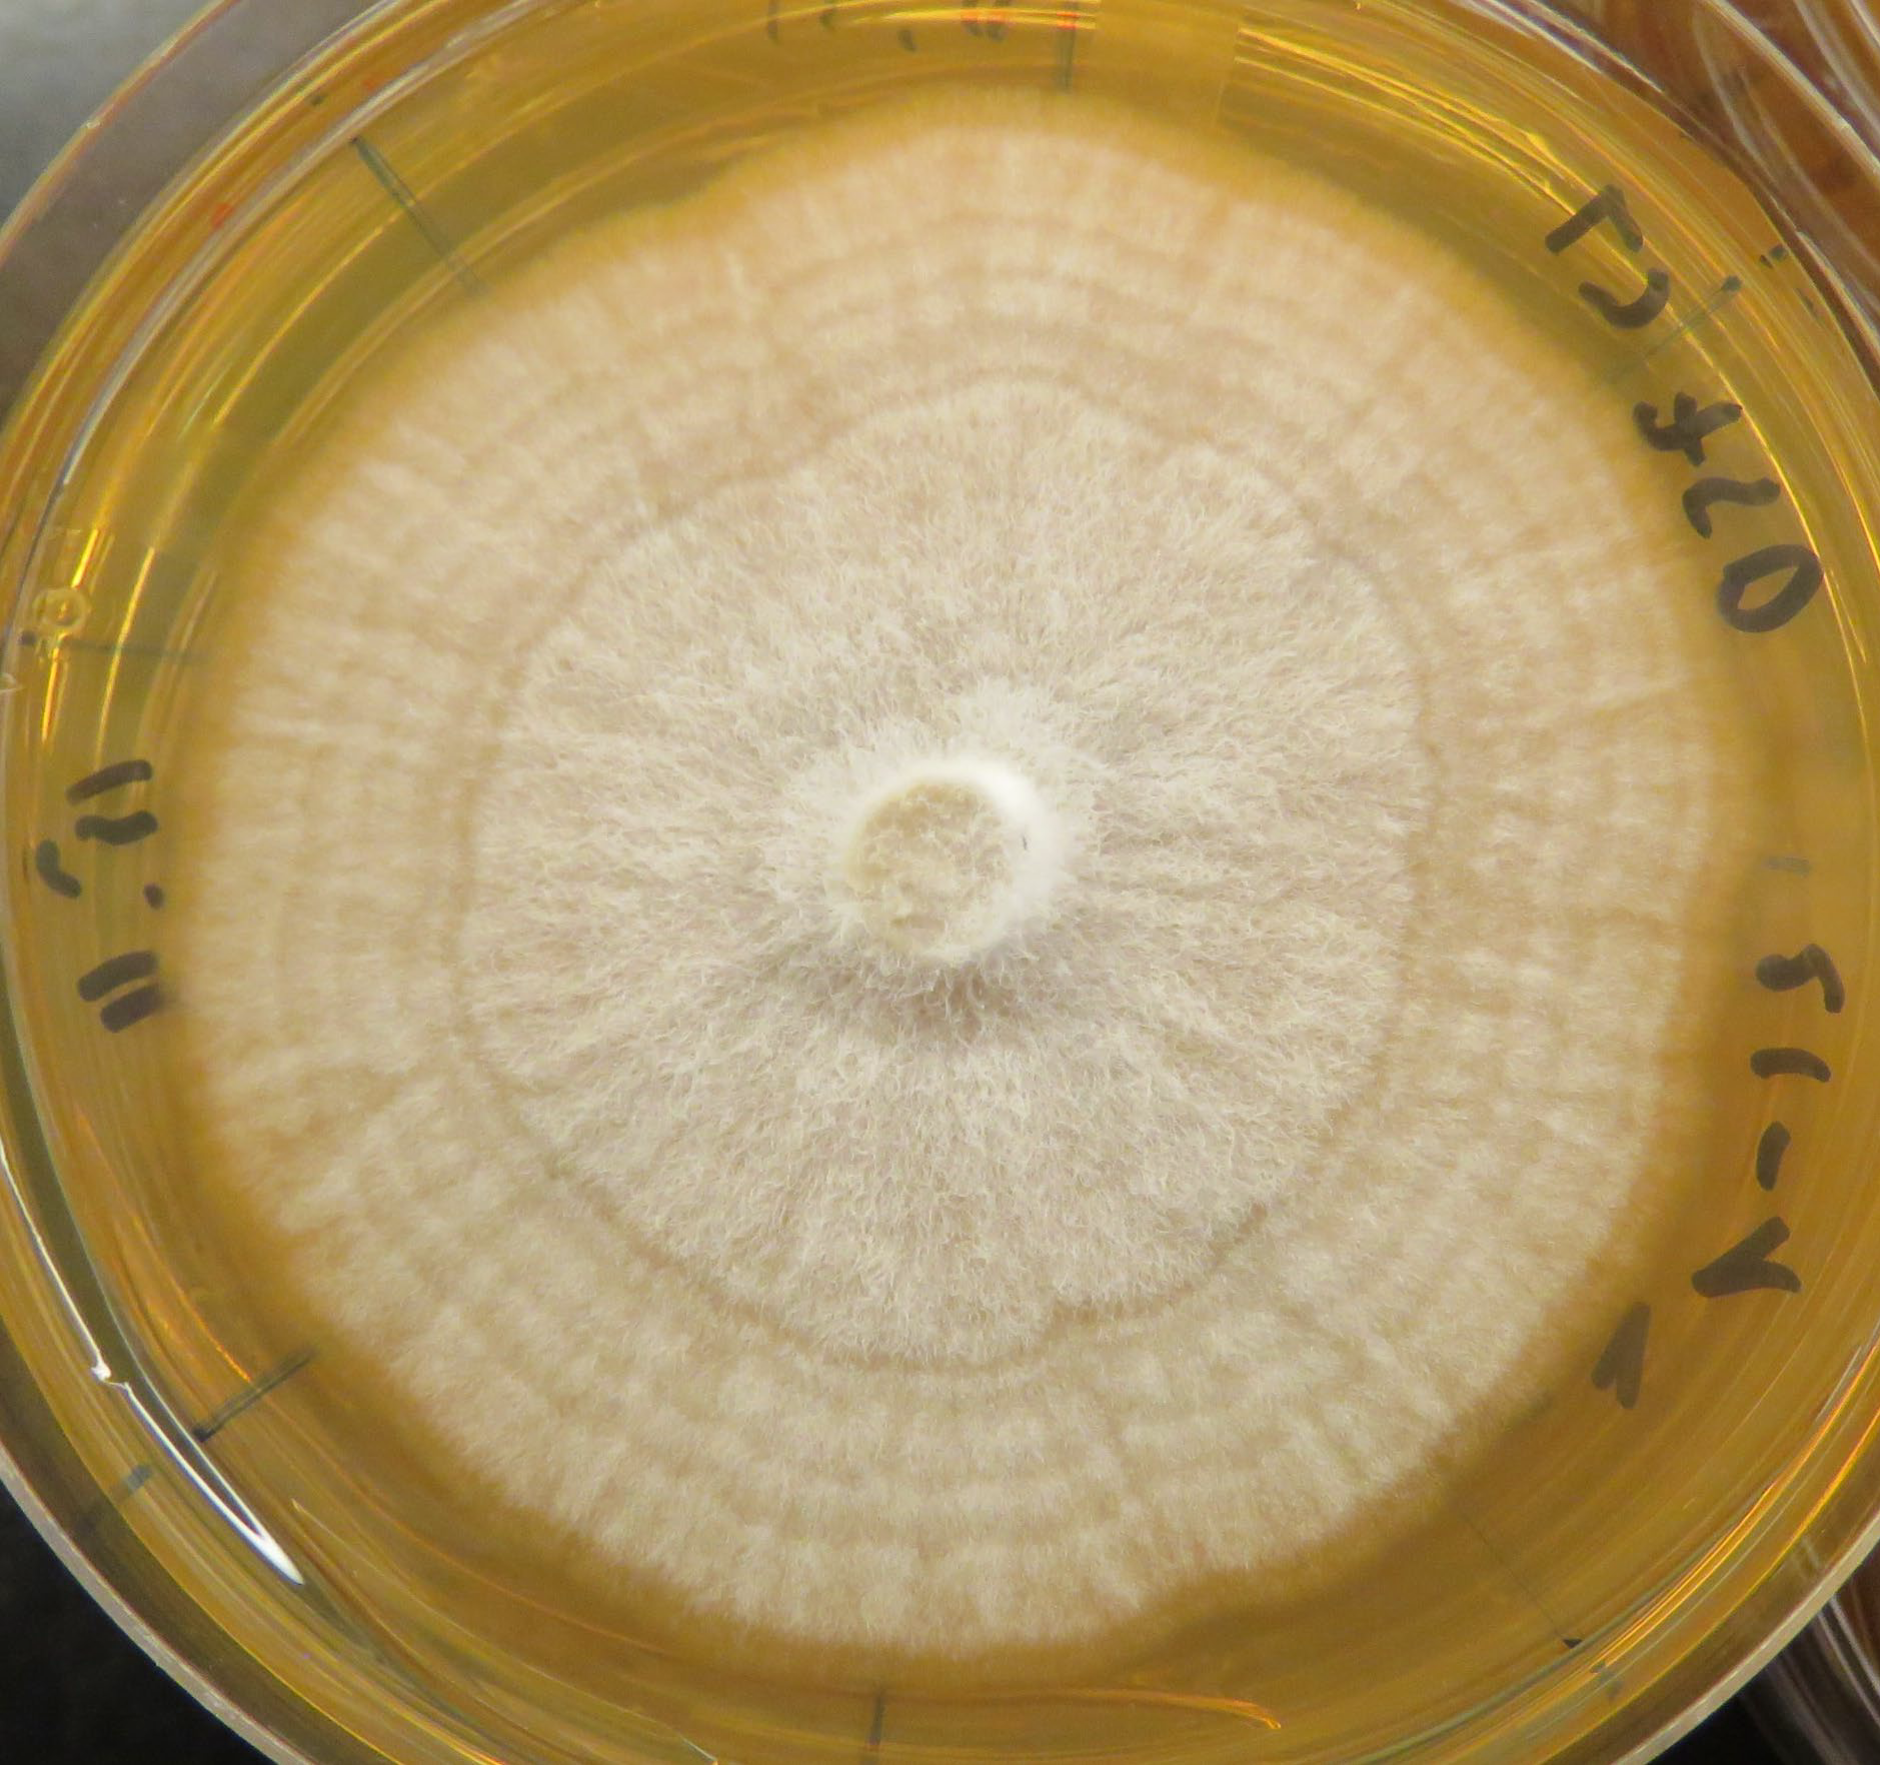

This lecture explores how sentinel plantings serve as an early-warning system for identifying potential pests and pathogens before they reach new regions or hosts. Students will learn how data from sentinel sites can inform risk assessment, support rapid detection of harmful organisms, and provide critical information for initiating targeted tree breeding programs. The lecture highlights species selection, monitoring strategies, and the integration of sentinel observations into long-term improvement efforts aimed at enhancing resistance and ensuring resilient future forests.
Keywords: Sentinel plantings, Early detection, Tree breeding, Biosecurity, Pest and pathogen surveillance